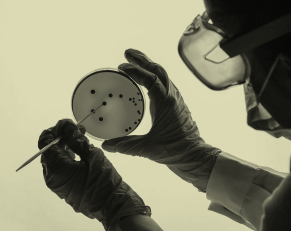

Peer reviews
Mother Dose™ Prenatal Multivitamin
"This supplement clearly values the key needs of pregnant women. From considering how well it would be tolerated to making it accessible to all women, I believe this will be an essential recommendation for women who are planning or are already pregnant."
—Sarah Tapp, Registered Midwife
"Thank you for doing something that is so important for Australian women and future generations. Our health starts in utero and this program will help 1000s of additional women give their children the best start in life. This is transgenerational healthcare at its best."
—Elizabeth Maxwell, MD. Obstetrician and Fertility Consultant
"Mother Dose™ is a fantastic choice; it’s high-quality, evidence-based, and formulated with the highest choline dosage on the market. Knowing that your purchase also helps provide essential prenatal vitamins to underserved Australian women makes it even more meaningful."
—Freya Lawler, Naturopath
"At last, support for cells that need real food and wholesome ingredients that are safe for mother and safe for their growing baby. A supplement that will prepare her body to bring her baby into the world in better condition."
—Fiona Reid, Registered Midwife
"Land Lab’s prenatal formula ticks all the boxes of a great prenatal supplement. It delivers high-quality nutrients and vitamins through a bioavailable formula."
—Sarah O'Donoghue, Registered Midwife
"This formulation is highly bioavailable, and the herbals included are wonderful in supporting women through preconception, pregnancy, and beyond. I love the addition of Australian Kakadu Plum to support not only pregnancy but antioxidant status, skin and immune health."
—Riley Hunt, Naturopath
"Empowering every mother with the highest quality, evidence-based supplements, supporting better health outcomes for all, from preconception through to breastfeeding."
—Ashleigh Frencham, Registered Midwife
"A great combination of elements needed to support women thrive in pregnancy, motherhood, and beyond."
—Rose Whitfield, Registered Midwife
"Mother Dose™ provides access to the best natural ingredients for a healthy pregnancy while ensuring that every woman, regardless of her circumstances, can benefit from essential prenatal support."
—Kate Dalton, Naturopath
DOCTOR FORMULATED
PRECISION IN EVERY DOSE
BACKED BY SCIENCE


"Many prenatal supplements on the market do not meet the daily recommended intake for pregnancy or do not contain good-quality sources of nutrients.
"As a midwife, I am happy to recommend this product to all pregnant women. This is because this prenatal supplement meets the recommended levels for particularly important nutrients in pregnancy & breastfeeding in forms that can be well absorbed by the body with few side effects. I love that this contains a natural source of vitamin C from Kakadu Plum."
—Michaela Suddick, Registered Midwife
Peer reviews
Mother Dose™ Prenatal Multivitamin
"The intentionally iron-free formulation will be attractive to many women, especially when feeling nauseous in the first and second trimester. There has been nothing like this on the market."
—Susanne Armour, Registered Midwife
"This formulation simplifies the complex area of pregnancy supplementation. This will reduce so much stress for women who are trying to meet their individual needs from multiple different products. This formulation has really considered the evidence for a broader population."
—Nikki Preiner, Registered Dietitian
"This product has been so thoughtfully crafted to nourish the body with nutrients that are easily absorbed. The addition of traditional Indigenous ingredients and consideration of addressing morning sickness really highlights how much care was taken to nurture women’s bodies through conception and pregnancy."
—Alex Thomson, Registered Midwife
"Land Lab has created a high quality formulation covering the essentials I recommend for preconception, pregnancy and beyond. I often recommend added choline to my fertility and pregnancy clients so having it in the one formula is a game changer."
—Brooke Oke, Naturopath
"This prenatal supplement offers high-quality, bioavailable ingredients, making it an excellent choice for a prenatal. By bridging the gap between premium nutrition and affordability, Land Lab is helping more women access the essential nutrients needed for a healthy pregnancy and baby."
—Jess Rinehart, fertility nutritionist
"As a midwife, it’s important for me to recommend supplements that will support a woman’s pregnancy well, not just a standardized approach. After thoroughly reading the evidence and ingredients of Land Lab Pre Natal, I wouldn’t hesitate to recommend to the women I see in my clinic. Great bioavailability, no nasties, all the good stuff and more!"
—Amanda Schenk, Midwife
TRANSFORM YOUR HEALTH WITH OuR SCIENCE